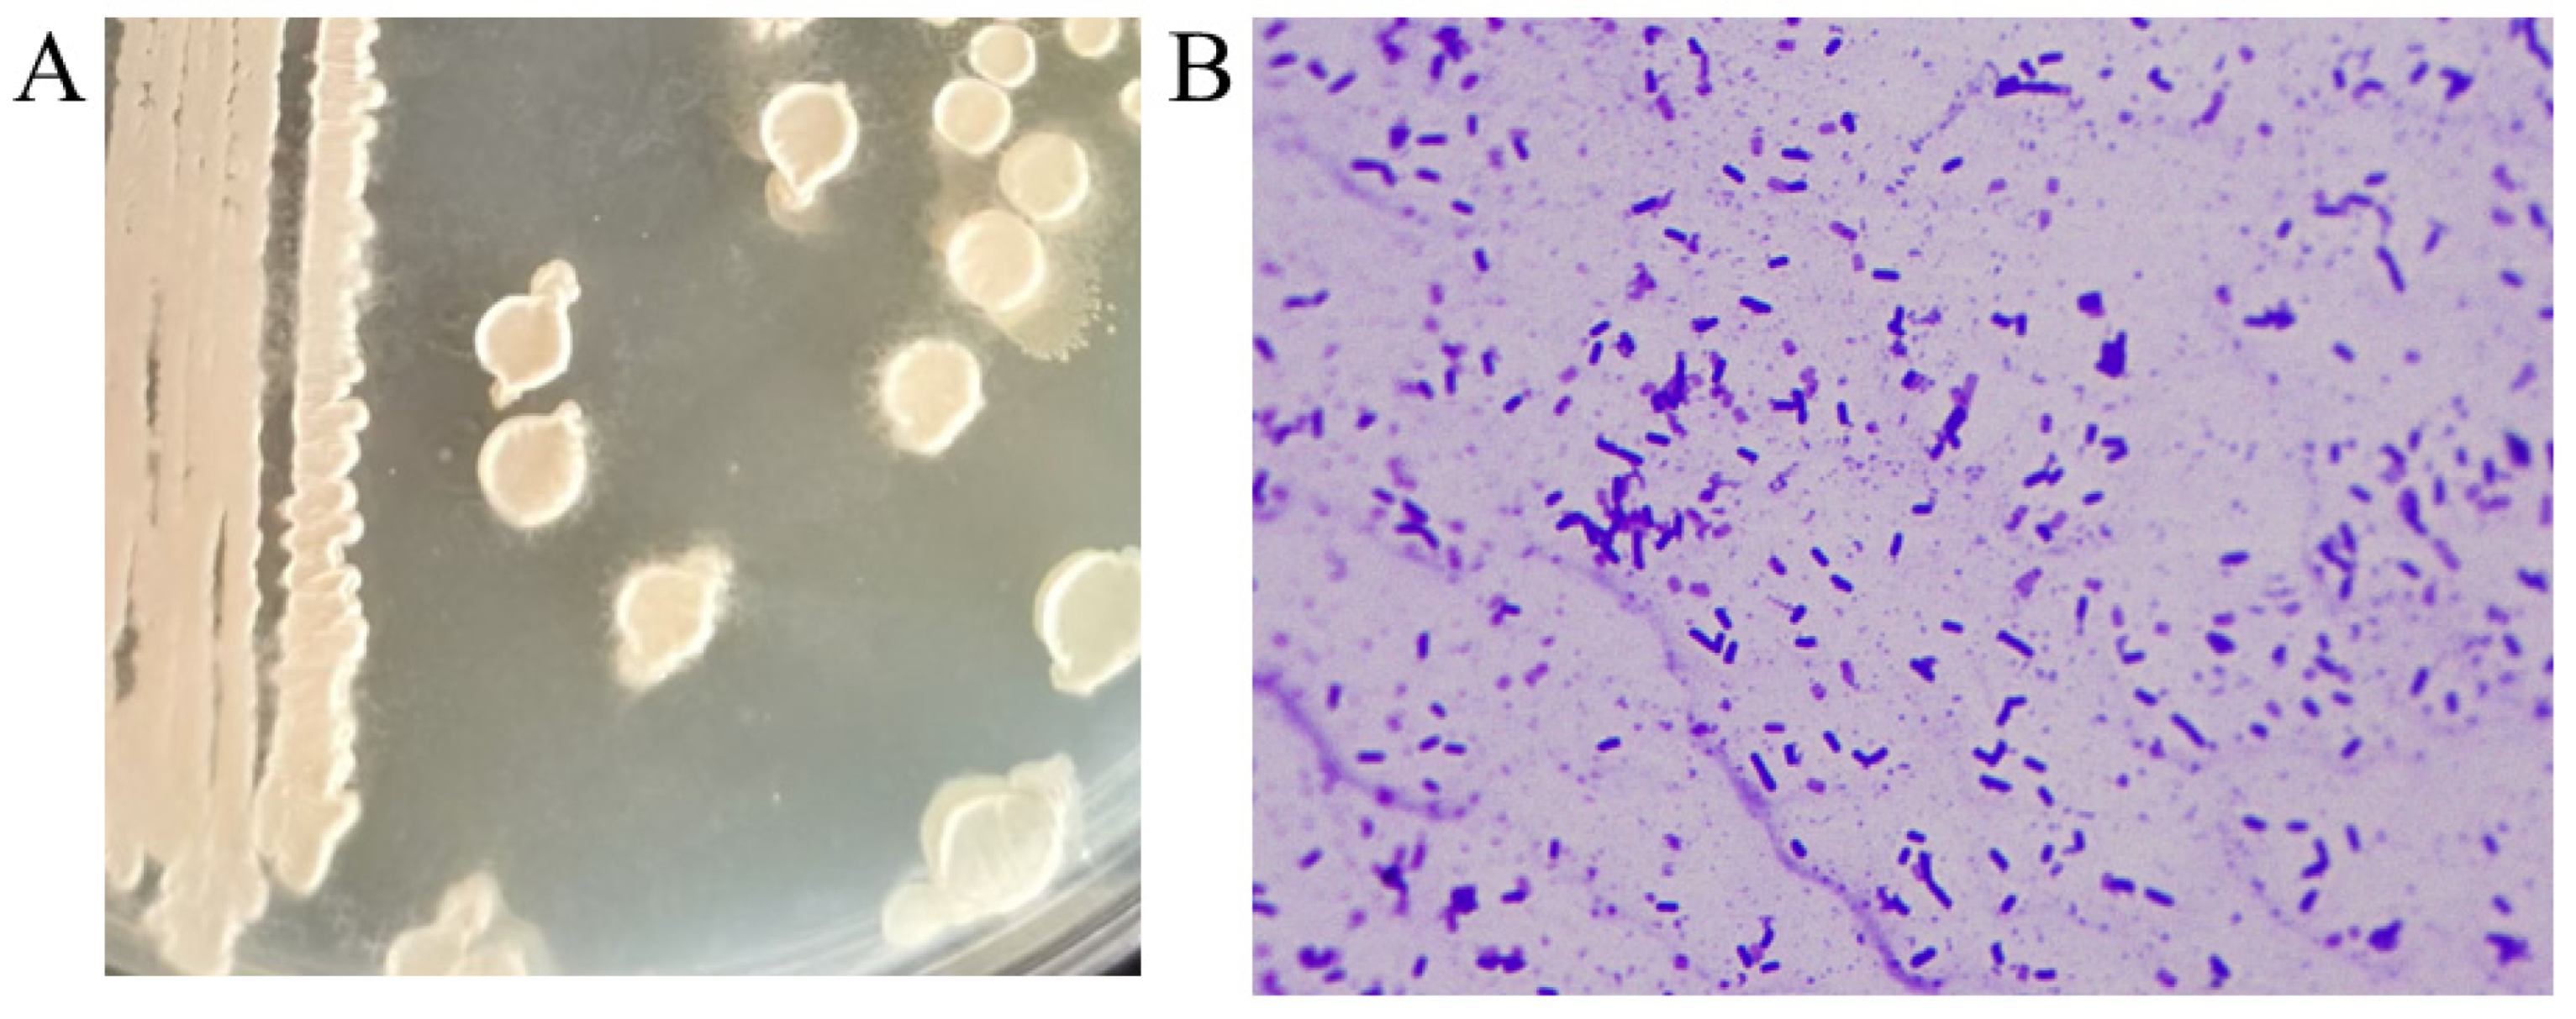
Fermentation 11 00137 g002
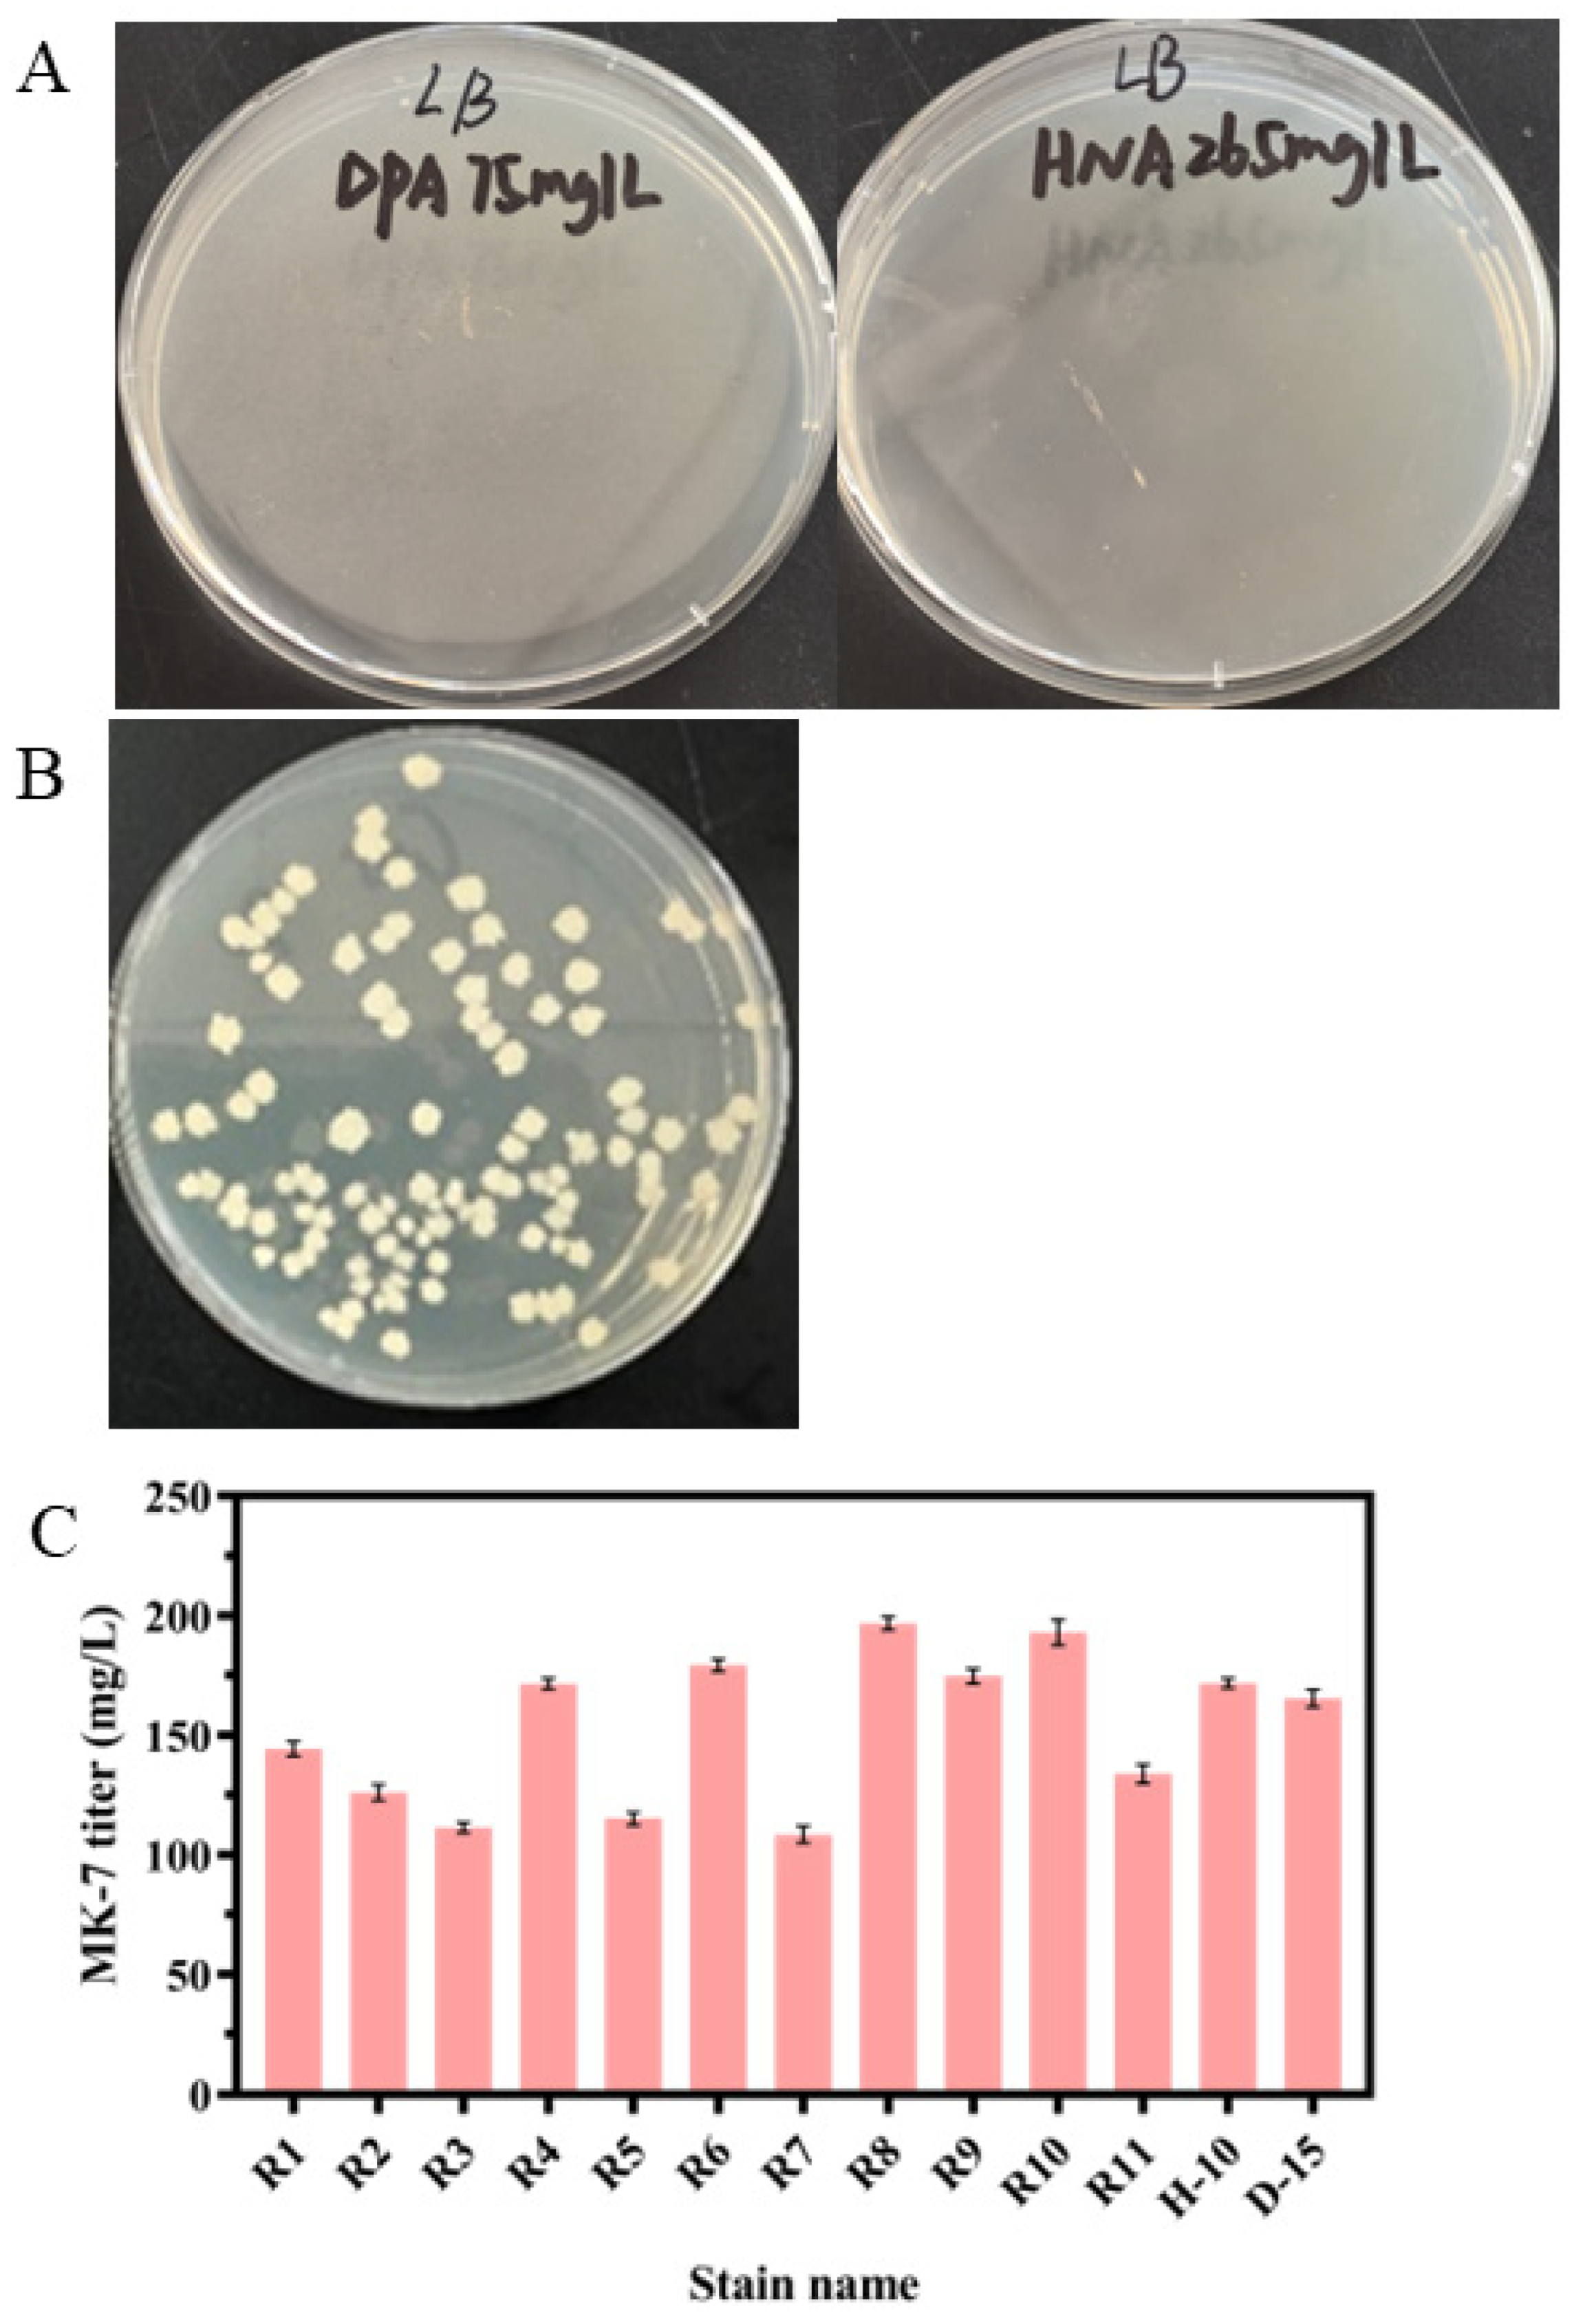
Fermentation 11 00137 g005

Synergistic Optimization of Bacillus subtilis for Efficiently Producing Menaquinone-7 (MK-7) by Atmospheric and Room Temperature Plasma (ARTP) Mutagenesis and Metabolic Engineering
Abstract
1. Introduction
2. Materials and Methods
2.1. Experimental Materials
2.2. Strains and Plasmids
2.3. Media and Cultivation Conditions
2.3.1. Media
2.3.2. Main Solutions
2.3.3. Cultivation Methods
2.4. Isolation and Screening of Wild-Type Bacillus subtilis for MK-7 Production
2.5. ARTP Mutagenesis
2.6. Protoplast Fusion
2.7. Whole-Genome Sequencing of Wild-Type Bacillus subtilis
2.8. Fibrinolytic Enzyme Activity Assay
2.9. Analytical Method
3. Results and Discussion
3.1. Isolation and Identification of MK-7-Producing Strains
- Six strains with large transparent zones were selected and named L-1, L-2, L-3, L-4, L-5, and L-6. The diameters of the transparent zones were measured, and each of these six strains was inoculated into fermentation medium. The fibrinolytic activity and MK-7 synthesis capability of the strains were calculated based on the standard curves for urokinase and MK-7, respectively. The results are shown in Table 2. The strain with the highest MK-7 production, L-5, was selected for subsequent experiments.
| Sample Name | L-1 | L-2 | L-3 | L-4 | L-5 | L-6 |
|---|---|---|---|---|---|---|
| Urokinase activity (IU/mL) | 628.48 | 566.59 | 592.89 | 628.48 | 646.49 | 584.09 |
| MK-7 titer (mg/L) | 45.01 | 68.64 | 64.05 | 53.38 | 75.18 | 44.07 |
- The isolated high-titer strain was streaked onto LB agar plates and incubated at 37 °C for 12 h to observe colony characteristics. The colony surface was rough, opaque, and white or slightly yellow, with wrinkles forming around the colony after another 12 h of incubation (Figure 2A). When inoculated into liquid culture and incubated at 37 °C for 12 h, the culture exhibited a characteristic foul odor reminiscent of rotten eggs. Gram staining indicated that the strain was Gram-positive, and microscopic examination revealed rod-shaped bacteria (Figure 2B). Physiological and biochemical identification of the strain was performed, and the results are summarized in Table 3. Based on the physiological and biochemical characteristics, and in comparison with the Bergey’s Manual of Determinative Bacteriology and the Manual of Common Bacteria Identification, the strain was preliminarily identified as Bacillus subtilis.
| Experimental Project | Result |
|---|---|
| Voges–Proskauer (V-P) test | + |
| Lactose | - |
| Glucose | + |
| Maltose | + |
| Sucrose | + |
| Mannitol | - |
| Hydrogen sulfide production test | - |
- The 16S rRNA sequencing results are presented in Supplementary S1.1, with a total sequence length of 1465 bp. The sequence was compared with the NCBI database, and a phylogenetic tree was constructed using the MEGA11 software (Figure 3). The results indicated that the isolated strain L-5 clustered in the same branch as Bacillus subtilis 168, with a close phylogenetic relationship. Based on the morphological characteristics of the bacteria, colony morphology, growth behavior on media, and the results from both morphological and biochemical identifications, the strain was confirmed to be Bacillus subtilis.Figure 3. The phylogenetic tree constructed based on the 16S rRNA sequencing results of strain L-5.
3.2. Screening of the MK-7-Producing Strain for Resistance to HNA or DPA by ARTP
3.3. Screening of the MK-7-Producing Strain for Resistance to HNA and DPA by Protoplast Fusion
3.4. Genomic Analysis and Identification of Key Gene Mutations
3.5. Overexpression of Mutant Genes Increases the Production of MK-7
4. Conclusions
Supplementary Materials
Author Contributions
Funding
Institutional Review Board Statement
Informed Consent Statement
Data Availability Statement
Conflicts of Interest
References
- Fujita, Y.; Iki, M.; Tamaki, J.; Kouda, K.; Yura, A.; Kadowaki, E.; Sato, Y.; Moon, J.S.; Tomioka, K.; Okamoto, N.; et al. Association between vitamin K intake from fermented soybeans, natto, and bone mineral density in elderly Japanese men: The Fujiwara-kyo Osteoporosis Risk in Men (FORMEN) study. Osteoporos. Int. 2012, 23, 705–714. [Google Scholar] [CrossRef]
- Azarkina, N.; Konstantinov, A.A. Stimulation of menaquinone-dependent electron transfer in the respiratory chain of Bacillus subtilis by membrane energization. J. Bacteriol. 2002, 184, 5339–5347. [Google Scholar] [CrossRef]
- Theuwissen, E.; Magdeleyns, E.J.; Braam, L.A.J.L.M.; Teunissen, K.J.; Knapen, M.H.; Binnekamp, I.A.G.; van Summeren, M.J.H.; Vermeer, C. Vitamin K status in healthy volunteers. Food Funct. 2014, 5, 229–234. [Google Scholar] [CrossRef]
- Matschiner, J.T.; Doisy, E.A., Jr. Bioassay of vitamin K in chicks. J. Nutr. 1966, 90, 97–100. [Google Scholar] [CrossRef] [PubMed]
- Schurgers, L.J.; Teunissen, K.J.F.; Hamulyák, K.; Knapen, M.H.J.; Vik, H.; Vermeer, C. Vitamin K–containing dietary supplements: Comparison of synthetic vitamin K1 and natto-derived menaquinone-7. Blood 2006, 109, 3279–3283. [Google Scholar] [CrossRef] [PubMed]
- Tarvainen, M.; Fabritius, M.; Yang, B.R. Determination of vitamin K composition of fermented food. Food Chem. 2019, 275, 515–522. [Google Scholar] [CrossRef] [PubMed]
- Bentley, R.; Meganathan, R. Biosynthesis of vitamin K (menaquinone) in bacteria. Microbiol. Rev. 1982, 46, 241–280. [Google Scholar] [CrossRef] [PubMed]
- Sato, T.; Yamada, Y.; Ohtani, Y.; Mitsui, N.; Murasawa, H.; Araki, S. Production of menaquinone (vitamin K2)-7 by Bacillus subtilis. J. Biosci. Bioeng. 2001, 91, 16–20. [Google Scholar] [CrossRef]
- Liu, K.; Fang, H.; Cui, F.; Nyabako, B.A.; Tao, T.; Zan, X.; Chen, H.; Sun, W. ARTP mutation and adaptive laboratory evolution improve probiotic performance of Bacillus coagulans. Appl. Microbiol. Biotechnol. 2020, 104, 6363–6373. [Google Scholar] [CrossRef] [PubMed]
- Takahashi, I.; Ogura, K.; Seto, S. Heptaprenyl pyrophosphate synthetase from Bacillus subtilis. J. Biol. Chem. 1980, 255, 4539–4543. [Google Scholar] [CrossRef]
- Tsukamoto, Y.; Kasai, M.; Kakuda, H. Construction of a Bacillus subtilis (natto) with high productivity of vitamin K2 (menaquinone-7) by analog resistance. Biosci. Biotechnol. Biochem. 2001, 65, 2007–2015. [Google Scholar] [CrossRef] [PubMed]
- Li, C.L.; Li, M.; Zhang, W.G.; Xu, J.Z. Accelerating the menaquinone-7 production in Bacillus amyloliquefaciens by optimization of the biosynthetic pathway and medium components. Syst. Microbiol. Biomanuf. 2023, 3, 776–791. [Google Scholar] [CrossRef]
- Xu, J.Z.; Zhang, W.G. Menaquinone-7 production from maize meal hydrolysate by Bacillus isolates with diphenylamine and analogue resistance. J. Zhejiang Univ. -Sci. B 2017, 18, 462–473. [Google Scholar] [CrossRef] [PubMed]
- Ma, Y.W.; McClure, D.D.; Somerville, M.V.; Proschogo, N.W.; Dehghani, F.; Kavanagh, J.M.; Coleman, N.V. Metabolic Engineering of the MEP Pathway in Bacillus subtilis for Increased Biosynthesis of Menaquinone-7. ACS Synth. Biol. 2019, 8, 1620–1630. [Google Scholar] [CrossRef] [PubMed]
- Yang, S.M.; Cao, Y.X.; Sun, L.M.; Li, C.F.; Lin, X.; Cai, Z.G.; Zhang, G.; Song, H. Modular Pathway Engineering of Bacillus subtilis To Promote De Novo Biosynthesis of Menaquinone-7. ACS Synth. Biol. 2019, 8, 70–81. [Google Scholar] [CrossRef] [PubMed]
- Kong, M.K.; Lee, P.C. Metabolic engineering of menaquinone-8 pathway of Escherichia coli as a microbial platform for vitamin K production. Biotechnol. Bioeng. 2011, 108, 1997–2002. [Google Scholar] [CrossRef] [PubMed]
- Guerrero, R. Bergey’s manuals and the classification of prokaryotes. Int. Microbiol. Off. J. Span. Soc. Microbiol. 2001, 4, 103–109. [Google Scholar] [CrossRef] [PubMed]
- Zhang, X.; Zhang, C.; Zhou, Q.Q.; Zhang, X.F.; Wang, L.Y.; Chang, H.B.; Li, H.P.; Oda, Y.; Xing, X.H. Quantitative evaluation of DNA damage and mutation rate by atmospheric and room-temperature plasma (ARTP) and conventional mutagenesis. Appl. Microbiol. Biotechnol. 2015, 99, 5639–5646. [Google Scholar] [CrossRef]
- Chen, L.; Chong, X.Y.; Zhang, Y.Y.; Lv, Y.Y.; Hu, Y.S. Genome shuffling of Bacillus velezensis for enhanced surfactin production and variation analysis. Curr. Microbiol. 2020, 77, 71–78. [Google Scholar] [CrossRef]
- Astrup, T.; Mullertz, S. The fibrin plate method for estimating fibrinolytic activity. Arch. Biochem. Biophys. 1952, 40, 346–351. [Google Scholar] [CrossRef]
- Cui, S.X.; Lv, X.Q.; Wu, Y.K.; Li, J.H.; Du, G.C.; Ledesma-Amaro, R.; Liu, L. Engineering a Bifunctional Phr60-Rap60-Spo0A Quorum-Sensing Molecular Switch for Dynamic Fine-Tuning of Menaquinone-7 Synthesis in Bacillus subtilis. ACS Synth. Biol. 2019, 8, 1826–1837. [Google Scholar] [CrossRef] [PubMed]
- Jiang, C.; Zhao, G.; Wang, H.; Zheng, W.; Zhang, R.; Wang, L.; Zheng, Z. Comparative genomics analysis and transposon mutagenesis provides new insights into high menaquinone-7 biosynthetic potential of Bacillus subtilis natto. Gene 2024, 907, 148264. [Google Scholar] [CrossRef] [PubMed]
- Min, X.; Guo, L.; Li, L.; Yang, R.; Zhao, W.; Lyu, X. Comparative transcriptome analysis reveals the underlying mechanism for over-accumulation of menaquinone-7 in Bacillus subtilis natto mutant. Biochem. Eng. J. 2021, 174, 108097. [Google Scholar] [CrossRef]
- Huang, W.; Li, J.; Zhu, Q.; Lv, J.; Zhu, R.; Pu, C.; Zhao Hua, B.; Fu, G.; Zhang, D. Increasing Vitamin K2 Synthesis in Bacillus subtilis by Controlling the Expression of MenD and Stabilizing MenA. J. Agric. Food Chem. 2024, 72, 22672–22681. [Google Scholar] [CrossRef] [PubMed]
- Li, C.; Wang, H.; Wang, L.; Wang, P.; Zheng, Z. Enhancement of MK-7 synthesis by engineered strains of Bacillus subtilis natto that overexpress men genes and by increasing available dissolved oxygen. Chin. J. Appl. Environ. Biol. 2022, 28, 1393–1399. [Google Scholar] [CrossRef]
- Ding, X.; Zheng, Z.; Zhao, G.; Wang, L.; Wang, H.; Yang, Q.; Zhang, M.; Li, L.; Wang, P. Bottom-up synthetic biology approach for improving the efficiency of menaquinone-7 synthesis in Bacillus subtilis. Microb. Cell Factories 2022, 21, 101. [Google Scholar] [CrossRef] [PubMed]
- Liu, Y.; Ding, X.-M.; Xue, Z.-L.; Hu, L.-X.; Cheng, Q.; Chen, M.-H.; Su, Y.; Zhu, B.; Xu, P. Site-directed mutagenesis of UbiA to promote menaquinone biosynthesis in Elizabethkingia meningoseptica. Process Biochem. 2017, 58, 186–192. [Google Scholar] [CrossRef]

| Strain and Plasmid | Description | Source |
|---|---|---|
| Strain | ||
| Escherichia coli JM110 | Cloning host | Beyotime |
| L-5 | Wild-type Bacillus subtilis | This study |
| H-10 | 1-Hydroxy-2-naphthoic acid resistance mutant | This study |
| D-15 | Diphenylamine resistance mutant | This study |
| R-8 | Diphenylamine and 1-hydroxy-2-naphthoic acid resistance mutant | This study |
| R-81 | Strain R-8 harboring the pMA5-menDWT | This study |
| R-82 | Strain R-8 harboring the pMA5-menAWT | This study |
| R-83 | Strain R-8 harboring the pMA5-DxsWT | This study |
| R-84 | Strain R-8 harboring the pMA5-DxrWT | This study |
| R-85 | Strain R-8 harboring the pMA5-menDMT | This study |
| R-86 | Strain R-8 harboring the pMA5-menAMT | This study |
| R-87 | Strain R-8 harboring the pMA5-DxsMT | This study |
| R-88 | Strain R-8 harboring the pMA5-DxrMT | This study |
| R-89 | Strain R-8 harboring the pMA5-menA-menD-Dxs-DxrMT | This study |
| Plasmid | ||
| pMA5 | The pMA5 is an E. coli/B. subtilis shuttle plasmid that is mainly used for protein expression in B. subtilis. Ampr Kmr | Thermo Fisher Scientific |
| pMA5-menDWT | pMA5 with menD, in which the gene menD is derived from the wild-type strain L-5 | This study |
| pMA5-menAWT | pMA5 with menA, in which the gene menA is derived from the wild-type strain L-5 | This study |
| pMA5-DxsWT | pMA5 with Dxs, in which the gene Dxs is derived from the wild-type strain L-5 | This study |
| pMA5-DxrWT | pMA5 with Dxr, in which the gene Dxr is derived from the wild-type strain L-5 | This study |
| pMA5-menDMT | pMA5 with menD, in which the gene menD is derived from the mutant strain R-8 | This study |
| pMA5-menAMT | pMA5 with menA, in which the gene menA is derived from the mutant strain R-8 | This study |
| pMA5-DxsMT | pMA5 with Dxs, in which the gene Dxs is derived from the mutant strain R-8 | This study |
| pMA5-DxrMT | pMA5 with Dxr, in which the gene Dxr is derived from the mutant strain R-8 | This study |
| pMA5-menA-menD-Dxs-DxrMT | pMA5 with menA, menD, Dxs, and Dxr, in which the genes menA, menD, Dxs, and Dxr are derived from the mutant strain R-8 | This study |
| Gene Name | Base Changes | Mutation Results |
|---|---|---|
| Dxs | 78G to A, 178A to G, 555G to T, 560T to G, 1389C to G | N60Q, Q185H |
| Dxr | 915A to G, 11052C to A | Q351K |
| GlpD | None | None |
| MenA | 586T to C, 587C to T | S196L |
| MenD | 747 C to T, 765T to C | S249L |
| MenG | None | None |
| Fni | None | None |
| AroA | None | None |
Disclaimer/Publisher’s Note: The statements, opinions and data contained in all publications are solely those of the individual author(s) and contributor(s) and not of MDPI and/or the editor(s). MDPI and/or the editor(s) disclaim responsibility for any injury to people or property resulting from any ideas, methods, instructions or products referred to in the content. |
© 2025 by the authors. Licensee MDPI, Basel, Switzerland. This article is an open access article distributed under the terms and conditions of the Creative Commons Attribution (CC BY) license (https://creativecommons.org/licenses/by/4.0/).
Share and Cite
Li, M.; Li, J.; Li, Y.; Zhang, X.; Xu, J. Synergistic Optimization of Bacillus subtilis for Efficiently Producing Menaquinone-7 (MK-7) by Atmospheric and Room Temperature Plasma (ARTP) Mutagenesis and Metabolic Engineering. Fermentation 2025, 11, 137. https://doi.org/10.3390/fermentation11030137
Li M, Li J, Li Y, Zhang X, Xu J. Synergistic Optimization of Bacillus subtilis for Efficiently Producing Menaquinone-7 (MK-7) by Atmospheric and Room Temperature Plasma (ARTP) Mutagenesis and Metabolic Engineering. Fermentation. 2025; 11(3):137. https://doi.org/10.3390/fermentation11030137
Chicago/Turabian StyleLi, Meng, Jiachang Li, Yufei Li, Xian Zhang, and Jianzhong Xu. 2025. "Synergistic Optimization of Bacillus subtilis for Efficiently Producing Menaquinone-7 (MK-7) by Atmospheric and Room Temperature Plasma (ARTP) Mutagenesis and Metabolic Engineering" Fermentation 11, no. 3: 137. https://doi.org/10.3390/fermentation11030137
APA StyleLi, M., Li, J., Li, Y., Zhang, X., & Xu, J. (2025). Synergistic Optimization of Bacillus subtilis for Efficiently Producing Menaquinone-7 (MK-7) by Atmospheric and Room Temperature Plasma (ARTP) Mutagenesis and Metabolic Engineering. Fermentation, 11(3), 137. https://doi.org/10.3390/fermentation11030137

